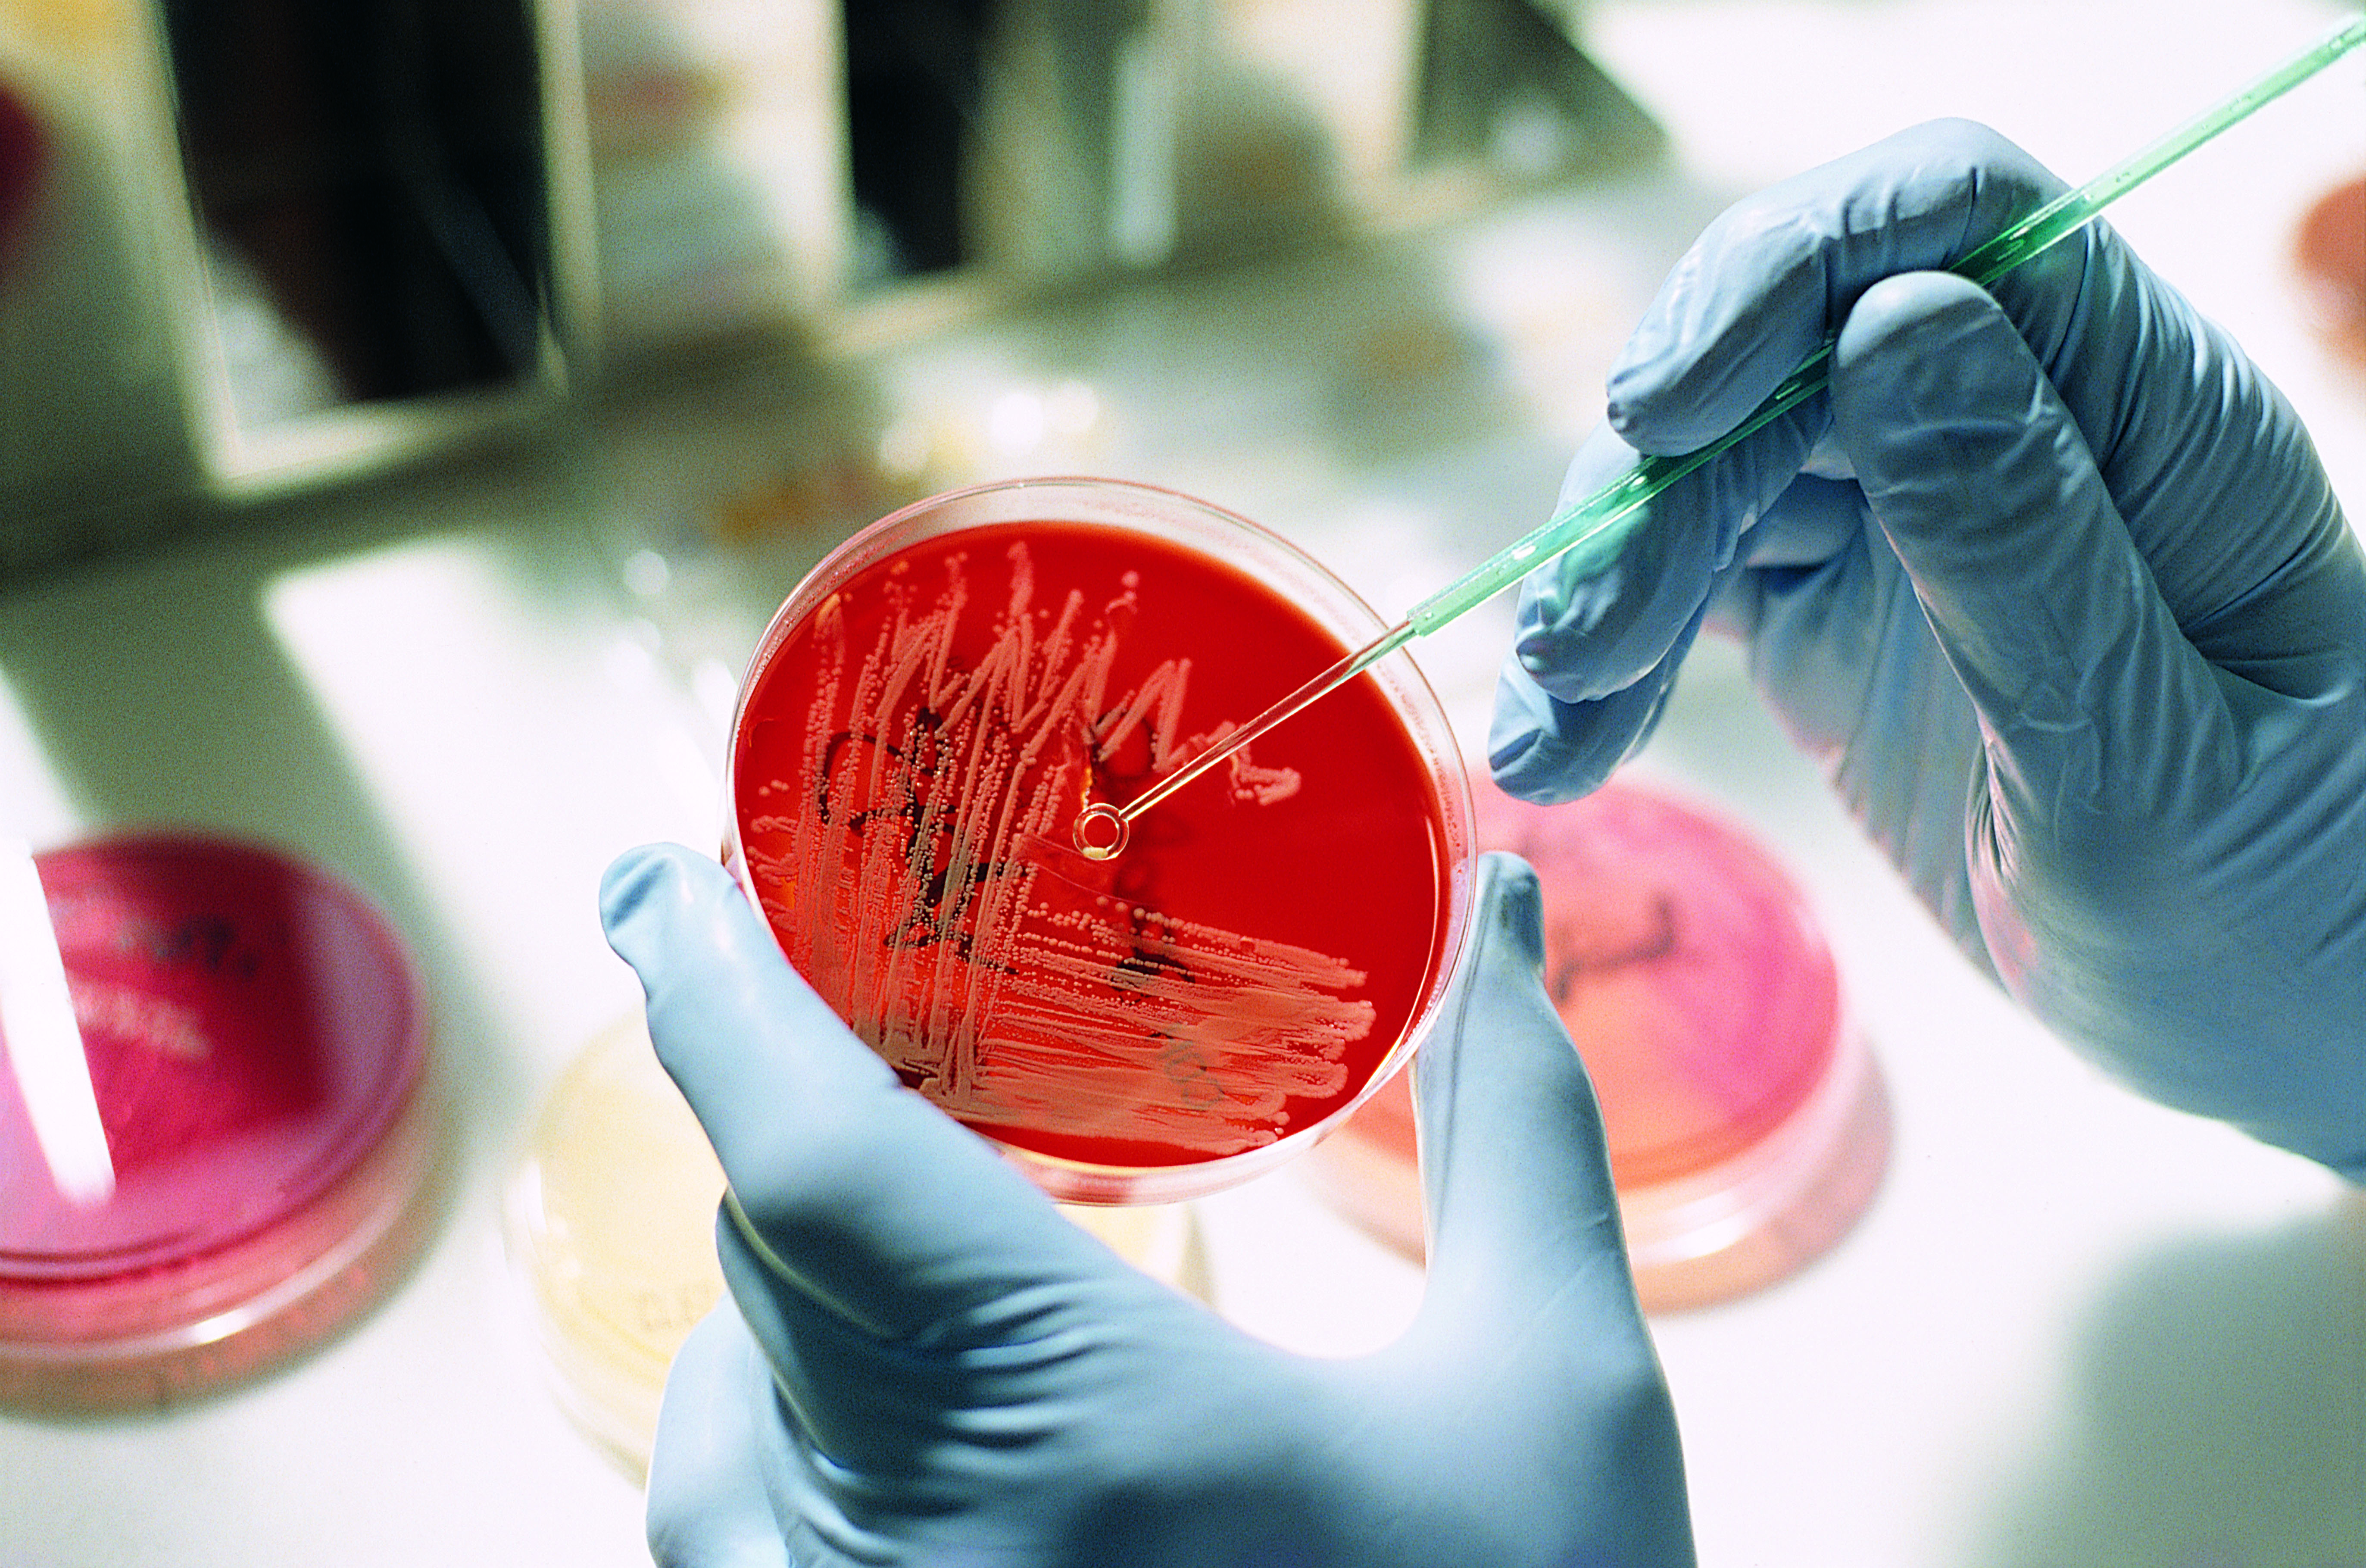
left

Welcome
Established in 2010, UCLA Health’s Antimicrobial Stewardship Program is led by Dr. Tara Vijayan and Dr. Ishminder Kaur. Our team is comprised of infectious disease physicians and pharmacists, microbiologists, outpatient parenteral antimicrobial therapy (OPAT) nurses, infection preventionists, data management specialists, and a quality improvement expert. Learn more about our team.
Consultation

For non-urgent questions about antimicrobials, please consider consultation. This service is intended to streamline and expedite questions to the Antimicrobial Stewardship Program. Questions appropriate for consultation can be found here.


